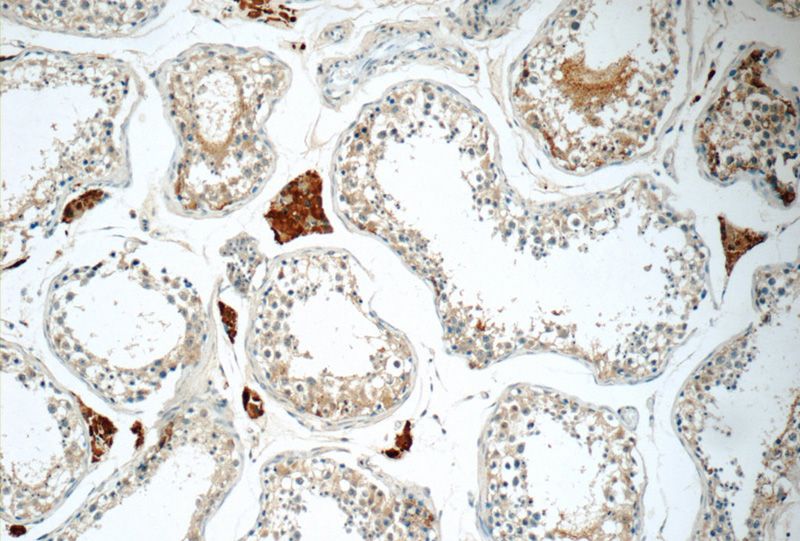

-
Product Name
CHMP1A antibody
- Documents
-
Description
CHMP1A Rabbit Polyclonal antibody. Positive IHC detected in human testis tissue, human brain tissue, human lung tissue, human placenta tissue, human skin tissue. Positive IF detected in HepG2 cells. Positive IP detected in HEK-293 cells. Positive WB detected in HEK-293 cells, A431 cells, HeLa cells, mouse kidney tissue, mouse lung tissue. Observed molecular weight by Western-blot: 33 kDa ,25 kDa
-
Tested applications
ELISA, WB, IHC, IP, IF
-
Species reactivity
Human, Mouse; other species not tested.
-
Alternative names
CHMP1 antibody; CHMP1A antibody; chromatin modifying protein 1A antibody; hVps46 1 antibody; KIAA0047 antibody; PCOLN3 antibody; PRSM1 antibody; Vps46 1 antibody
- Immunogen
-
Isotype
Rabbit IgG
-
Preparation
This antibody was obtained by immunization of CHMP1A recombinant protein (Accession Number: BC007527). Purification method: Antigen affinity purified.
-
Clonality
Polyclonal
-
Formulation
PBS with 0.02% sodium azide and 50% glycerol pH 7.3.
-
Storage instructions
Store at -20℃. DO NOT ALIQUOT
-
Applications
Recommended Dilution:
WB: 1:200-1:2000
IP: 1:200-1:2000
IHC: 1:20-1:200
IF: 1:50-1:500
-
Validations

HEK-293 cells were subjected to SDS PAGE followed by western blot with Catalog No:109231(CHMP1A antibody) at dilution of 1:500

IP Result of anti-CHMP1A (IP:Catalog No:109231, 3ug; Detection:Catalog No:109231 1:500) with HEK-293 cells lysate 880ug.
Immunohistochemistry of paraffin-embedded human testis tissue slide using Catalog No:109231(CHMP1A Antibody) at dilution of 1:50 (under 10x lens)

Immunohistochemistry of paraffin-embedded human testis tissue slide using Catalog No:109231(CHMP1A Antibody) at dilution of 1:50 (under 40x lens)

Immunofluorescent analysis of (-20oc Ethanol) fixed HepG2 cells using Catalog No:109231(CHMP1A Antibody) at dilution of 1:50 and Alexa Fluor 488-congugated AffiniPure Goat Anti-Rabbit IgG(H+L)
-
Background
Charged multivesicular body protein 1A (CHMP1A), also known as chromatin modifying protein 1A, is a member of the ESCRT-III (endosomal sorting complex required for transport III) complex which is involved in degradation of internalized transmembrane receptor proteins and formation of multivesicular bodies (MVBs) (PMID: 16730941). CHMP1A has both nuclear and cytoplasmic distributions (PMID: 11559748; 11559747). Subcellular localization of CHMP1A seems to vary depending on the cell type (PMID: 23023333). CHMP1A is required for MVBs formation and has a role in stable gene silencing within the nucleus. Besides, the tumor suppressor role of CHMP1A has also been reported (PMID: 18787405; 22261332).
-
References
- Scheffer LL, Sreetama SC, Sharma N. Mechanism of Ca²⁺-triggered ESCRT assembly and regulation of cell membrane repair. Nature communications. 5:5646. 2014.
Related Products / Services
Please note: All products are "FOR RESEARCH USE ONLY AND ARE NOT INTENDED FOR DIAGNOSTIC OR THERAPEUTIC USE"
